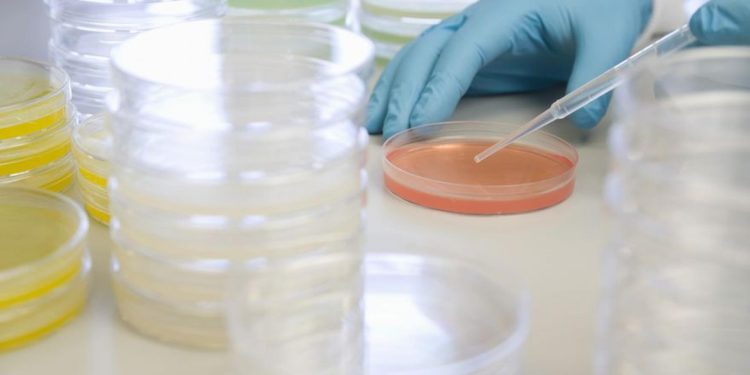
cholerae

La OMS advierte además de que la crisis climática influye en este resurgimiento del cólera, ya que a veces los brotes se producen tras desastres naturales tales como inundaciones o ciclones, cuya frecuencia está aumentando con el calentamiento global.
La enfermedad del cólera está resurgiendo en el mundo, con brotes cada vez más grandes y en más países, advirtió este viernes la Organización Mundial de la Salud (OMS) tras analizar las estadísticas más recientes.
Según estos datos, 44 países reportaron brotes de cólera en 2022, un 25 % más que en 2021, y entre ellos siete sufrieron epidemias que afectaron a más de 10.000 personas (Afganistán, Camerún, la República Democrática del Congo, Malaui, Nigeria, Somalia y Siria).
La OMS advierte además de que la crisis climática influye en este resurgimiento del cólera, ya que a veces los brotes se producen tras desastres naturales tales como inundaciones o ciclones, cuya frecuencia está aumentando con el calentamiento global.
El cólera es una infección intestinal aguda causada por una bacteria, que suele contraerse por la ingestión de alimentos o agua contaminados, habitualmente en lugares con malas condiciones de higiene, tales como zonas en conflicto o subdesarrolladas.
La agencia sanitaria de la Organización de las Naciones Unidas (ONU) solicitó a los Estados miembros y otros donantes 160 millones de dólares para responder al cólera en su plan de respuesta para emergencias 2023-2024.
Con información de EFE
Entérate también: Publicistas y organizadores de eventos presentan propuestas para reforma de ordenanzas tributaria